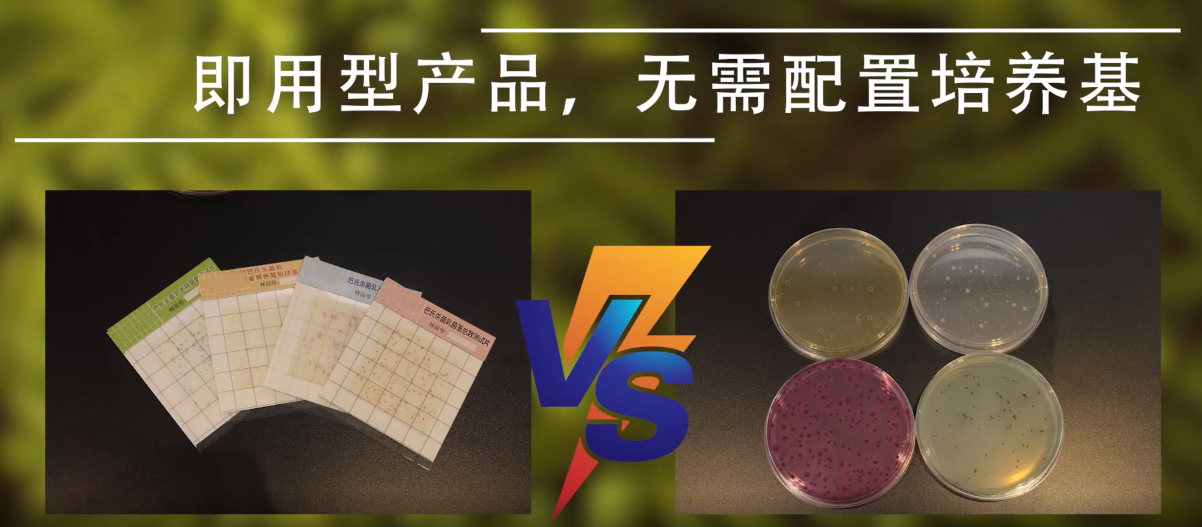
內容1.jpg

感谢您访问我们的网站,您可能还对以下资源感兴趣:慈溪概郝保安有限公司
狠狠色综合久久丁香婷婷,西西人体44WWW高清大胆,少妇宾馆粉嫩10p,未满十八勿入AV网免费,黄色a一级视频,国产三级精品福利久久,中文字幕无码不卡免费视频
,丁香花成人电影
网站地图
国产精品一线二线三线有什么区别
国产精品一区在线观看
亚洲国产精品无码中文字
免费大片一级a一级久久
久久天天躁狠狠躁夜夜97
dvd日本精品一区二区三区免费观看
色婷婷日韩精品视频在线播放
国产一级婬片免费播放
成人无码视频97免费
国产免费无码又爽又刺激高潮软件
国产精品免费久久久久电影
伦理电影在线观看
日韩专区+中文字幕
国产午夜福利1000集
亚洲AV无码不卡无码国产
日本韩国免费在线手机电影
亚洲精品tv久久久久久久久
日本欧美中文字幕精品一区
亚洲av日韩精品三区
中文有码亚洲制服av片
久久精品国产亚洲AV无
五月婷日韩中文字幕
免费看又黄又无码的网站
亚洲熟妇无码AV不卡在线播放
人人爽人人看
中文字幕乱码 亚洲精品
少妇偷人精品视频免费
日本在线 | 中文
激情综合五月开心婷婷
久久男人av资源网站无码不卡
免费看又黄又无码的网站
国产成人亚洲欧美
亚洲人成无码手机播放
777精品久无码人妻蜜桃
亚洲A无码综合A国产AV中文
久久精品分类视频
成全动漫视频在线观看
白人极品少妇XXXⅩ做受
国产人与ZOXXXX另类
精品欧美一区二区在线观看
免费av片大尺度在线观看
欧美日韩国产成人免费高清电影
国产男女爽爽爽免费视频
亚洲成人av在线系列
国产高清在线精品一区小说
真人做人试看60分钟免费视频
曰批免费视频播放免费直播
国产成人亚州在线线
午夜影院免费观看视频
欧美成人高清精品免费
精品国产三级a∨在线
男人av无码天堂
2020无码中文字幕
A一级片中文字幕
五月在线观看不卡
欧美一进一出抽搐大尺度视频
国产亚洲日韩欧美久久一区二区
97国产精华最好的产品
h肉动漫在线观看播放
亚洲中文字幕av天堂
国产精品久久久久7777按摩
日本护士毛茸茸
亚洲日韩精品无码专用网
亚洲国产中文综合一区二区三区
97精品在线免费视频观看
蜜臀AⅤ永久无码精品
久久久性无码久久久久
人妻在线视频免费观看
狠狠色综合播放一区二区
性一交一乱一伦一
亚洲图综合专区20p
欧美日韩中文无线码亚洲欧美中文日韩
日本人妻中文字幕久久久
91天仙tv国产福利精品
欧美日韩一区二区三区高清
亚洲一区二区av在线
人妻一区2区3区
樱桃视频大全免费观看
国产在线中文字幕
一本久道久久综合久久
九九在线视频精品九九一
久久国产精品一国产精品金尊
99久久夜色精品国产网站
国产99视频精品免
无码人妻一区二区三区免费
国产免费AV片在线观看浪潮
亚洲不卡无码AV大片
伊人俺去久久涩五月综合
东京热久久无码视频
日韩成av人片在线观看
中文字幕人妻无码一区二区三区
亚洲国产中文激情在线一区
国产香线蕉手机视频在线观看
亚洲国产成人精品无码区在线网站
伊人色综合网久久天天
欧美久久久久久
免费看又黄又无码的网站
一级 片内射在线视频播放
老女人AAA╳╳大片
五月天激情国产综合婷婷婷
亚洲黄色视频五月天
久久青青草原国产精品免费
h肉动漫在线观看播放
日韩国产二区不卡在线
国产video亚洲成人毛片
亚洲欧洲无码av图片
短裙公车被强好爽H吃奶视频
中国老太婆video
丁香六月色婷婷综合网
潮喷无码正在播放
日本中文字幕亚洲东京热
又粗又硬又黄又爽的免费视频
亚洲 日韩 五月 丁香
国产亚洲Aⅴ在线观看
欧美极品免费专区高清在线
性色av免费观看
日韩成av人片在线观看
国产又粗又大又爽视频
日本韩国免费在线手机电影
99久久99久久久精品齐齐
久久国产精品_国产精品
97久久人妻一区二区中文无码
日韩国产精品自在自线
四虎影院176
亚洲人成伊人成综合网久久久
黄色三级在线
黄色三级在线
国产高清视频a在线大全
中文热免费在线视频
国产免费女明星色视频
国产精品免费在线1
亚洲国产视频一级日韩欧美网站
国模大尺度啪啪
爱情岛网站亚洲禁18进入
国产91午夜福利精品
99久久伊人精品波多野结衣
亚洲欧洲无码av图片
琪琪视频在线观看
国产video亚洲成人毛片
性色av免费观看
欧美日韩国产成人免费高清电影
一本大道久东京无一二三区
无人区码一码二码三码区别新月
中文字幕在线无码
99精品国产一区二区三区
亚洲 欧美 日韩 制服 另类
欧美乱大交aaaa片if
欧美性色黄大片人与善
97人妻免费视频
国产亚洲精品第一综合另类
国产又滑又嫩又白
一区二区三区无码视频
伊人久久无码av一区二区三区
久久久久精品国产麻豆
国产4p精品观看
天堂8资源在线官网资源
中文av国语对白
日出水了特别黄的视频
国产无遮挡又黄又爽无VIP
A一级片中文字幕
国产黄片一区免费观看
激情综合亚洲色婷婷五月APP
少妇真人直播免费视频
欧美亚洲国产精品久久高清
国产初高中生真实在线视频
а√在线中文网新版地址在线
亚洲国产精品无码久久久蜜芽
黄色三级在线
日本道色综合久久影院
一二三四日本高清社区5
最新中文av岛国无码免费播放
56prom精品视频在放免费
处破女A片免费观看
A片免费观看国产片久久
菠萝菠萝蜜在线观看视频社区
菠萝菠萝蜜免费视频
A一级片中文字幕
亚洲伊人久久精品影院
国产一级婬片永久免费看
人人妻人人妻人人片色av
玩弄放荡人妻少妇系列视频
亚洲黄色视频五月天
国产精品永久免费
亚洲AV无码一区二区二三区入口
日日摸夜夜添夜夜添国产2021
欧美老熟妇506070乱子
午夜三级中文在线观看
人人爽人人爽人人片a免费
AV教师一区高清
人妻激情乱人伦视频
中文字幕乱码 亚洲精品
97国产无线乱码在线观看
91亚洲中文天堂在线播放
不卡国产视频第一页
性欧美长视频免费观看不卡
亚洲精品无码久久久久av麻豆
色先锋av影音先锋在线
国产一级特黄高清AAAA大片
午夜精品一区二区三区免费视频
国产精品成人va在线观看
在线精品国产一区二区三区
亚洲无码视频在线免费观看
亚洲中文字幕一区精品自拍
亚洲级αV无码毛片久久精品
国产美女厕所嘘嘘嘘嘘
曰本女人与公拘交酡
天天拍夜夜添久久精品
三级片国产免费播放
极品精品国产超清自在线观看
免费A级毛片无码视频
国产精品专区第五页
久久久精品人妻久久影视
97色伦亚洲国产中文
国产精品久久久久影院
国产av仑乱内谢
狠狠五月深爱婷婷网
国产中文一区二区
亚洲欧美日韩高清综合678
暖暖爱视频免费
久久香蕉国产线看观看精品蕉
精品欧洲AV无码一区二区三区
久久国产劲爆∧V内射
综合亚洲欧美日韩一区二区
色悠久久久久久久综合
最新精品国偷自产在线69
亚洲伊人久久精品影院
人与善性猛交Ⅹ
少妇被粗大的猛烈进出69影院一
精品一久久香蕉国产线看观
日本做受高潮好舒服视频
91精品国产福利姬喷水福利
婷婷色制服中文字幕
h肉动漫在线观看播放
亚洲日本中文字幕在线四区
青青草免费在线视频
精品无码人妻夜人多侵犯18
成全动漫视频在线观看
国产成人精品一 二区
高潮毛片无遮挡高清免费视频
国产午夜精品理论片
亚洲av日韩精品三区
亚洲国产另类久久久精品红牛
一级裸舞片欧美在线观看
国产无遮挡又黄又爽无VIP
久久青青草原国产毛片
免费国产VA在线观看
亚洲国产aⅴ成人精品无吗
欧美老妇bbbwwbbww
一色屋精品视频在线播放
亚洲AV成人中文无码专区
欧美大屁股xxxx高跟欧美黑
99国产精品国产精品九九
国产AV永久精品无码
99国产强伦姧在线看Rape
国产内射大片99
在线看片无码永久免费aⅴ
国产熟女高潮视频
日本丰满大乳人妻无码苍井空
国产午夜精品视频
在线看片无码永久免费aⅴ
国产天堂mv在线最新欧美久久久久久久高潮不断
国产精品一级18一级毛片
国产在线一区二区三区四区五区
久久精品欧美日韩精品图片
亚洲第一av无码天堂
91精品国产福利姬喷水福利
国产人与ZOXXXX另类
免费a级毛片无码专区
日本精品一区二区三区
99久久99久久久精品齐齐
成人精品一区二区三区中文字幕
亚洲AV无码国产综合专区
国产一区二区三区影院
人妻少妇被??得好爽好多水
寂寞人妻瑜伽被教练日
性色av免费观看
天天拍夜夜添久久精品
香蕉久久国产精品免
久久久无码精品亚洲日韩按摩
国产精品一区二区久久精品涩爱
亚洲第一av无码天堂
9l国产精品久久久久尤物
亚洲成a人片在线观看中文动漫
亚洲AV无码日韩精品影片
亚洲熟妇无码八AV在线播放
国产jizzjizz视频
亚洲欧美18岁网站
a视频在线观看
亚洲色偷偷色噜噜狠狠
成人免费在线播放av
国产欧美日韩一区二区三区在线
多人灌满精子怀孕高h
久久狠狠色噜噜狠狠狠狠97
用舌头去添高潮无码视频
久久精品亚洲精品无码金尊
国语自产偷拍精品视频偷拍
欢迎访问日韩精品一区二区三区影院
亚洲国产情侣偷自在线二页
欧美18ⅩXXXX性欧美喷水
国产综合精品久久久
大香伊蕉国产最新视频
亚洲va中文字幕无码
精品亚洲成AV人片在线观看ww
亚洲一区二区视频在线
亚洲色偷偷av
一本久道久久综合久久
2020青草国产9r在线
最近高清无吗免费看
AV无码免费岛国动作片
久久精品国产亚洲AV天海翼
国产午夜福利在线播放
国产中文一区二区
亚洲国产视频一级日韩欧美网站
麻豆果冻传媒av精品一区
精品日韩一区二区三区AV片
日韩高清中文字幕
中文字幕精品亚洲无线码一区应用
美女视频黄频大全免费
99久久国产综合精品五月天
成全动漫视频在线观看
国产尤物精品视频
中文字幕人妻少妇引诱隔壁
伊人久久大香线蕉av最新
中文字幕日韩有码av
国产果冻豆传媒麻婆精东
国产高潮白浆喷水
国产最新进精品视频
国产免费女明星色视频
亚洲AⅤ无码一区二区三区系列
a天天爽夜夜太爽视频精品
综合久久久久久久久久久
午夜福利电影网站鲁片大全
多乙亚洲国产中文综合
欧美xxxxhd高清
色五月丁香五月综合五月4438
久久精品免视国产
欧美精品xxxxbbbb
欧美 日韩 激情 一区二区三区
新版中文在线官网
内射人妻视频国内
国产精品久久久久影院
亚洲岛国成人免费av
av人摸人人人澡人人超碰下载
成熟人妻换XXXX
亚洲色欲在线观看欧美
香蕉久久国产精品免
国产婷婷精品av在线
久久久午夜精品福利内容
亚洲一区二区观看播放
色婷婷五月综合久久
中文字幕网在线网站
开心色播五月
国产a级毛片久久久久久精品
国产高潮白浆喷水
国产一区二区精品久久呦
最近中文字幕mv高清在线
精品国产三级a∨在线
a网站在线观看
亚洲AV无码精品无码麻豆
国产a国片精品青草社区
精品欧洲AV无码一区二区三区
国产2021中文天码字幕
天堂资源在线
四虎网址
99热精品久久只有精品
2020国产在线拍揄自揄视频
亚洲国产无套无码AV电影
亚洲另类国产欧美一区二区
99精品国产在热2019国产
国产人成精品午夜在线观看
国产午夜三级一区二区三
乌克兰大胆少妇BBW
GOGOGO高清在线观看免费韩国
日本丰满熟妇
久久久无码精品亚洲日韩按摩
日本丰满大乳人妻无码苍井空
中文字幕人妻无码一区二区三区
成熟人妻换XXXX
国产Va无码精品一区二区三区
国产av一区二区三区
激情久久五月天av无码
精品无码国产自产在线观看水浒传
国产精品自在线拍国产
色欲人妻AAAAAAA无码
成人乱码一区二区三区AV
亚洲精品无码18 在线
亚洲中字慕日产2020
日韩精品视频一区
大胆欧美熟妇xxbbwwbw
美女黄网站免费
亚洲欧洲国产日产
久久天天躁夜夜躁狠狠85麻豆
中文热免费在线视频
免费一级欧美片在线观看网站
99精品国产成人一区二区
97人妻免费视频
高清无码一区二区在线观看吞精
天天拍夜夜添久久精品
亚洲成人久久精品
无码免费中文字幕视频
中文字幕精品亚洲无线码一区应用
日韩欧美人妻综合
在线中文字幕人妻视频
99久久99久久精品免费看蜜桃
久久久噜噜噜久久免费
日本大胆欧美人术艺术
久久精品亚洲精品无码金尊
人人妻人人澡人人爽久久AV
一本狠狠色丁香婷婷综合久久
久久精品手机观看
a级免费视频
国产午夜人做人免费视频网站
国产jizzjizz全部免费看
无码中文字幕av免费放∨
精品国产自产在线观
在线观看欧美a级精品视频
伊人久久精品
亚洲欧美精品无码一区二区三区
综合亚洲欧美日韩一区二区
99久久国产综合精品五月天
国产毛片AV一区二区三区
亚洲AⅤ无码一区二区三区系列
熟妇人妻无码XXX视频
国产96在线 | 韩国
无码少妇一区二区三区
国产交换配乱婬视频偷最新章节
国产国产人成免费视频77777
国产午夜精品理论片
日本欧美一区二区三区在线播放
欧美日韩呦女一区二区三区
精品国产aⅴ无码一区二区91
香港台湾经典三级a视频
国产成人亚洲欧美91
国产精品ⅤA在线观看
免费久久人人爽人人爽av
国产成人精品一 二区
久久狠狠色噜噜狠狠狠狠97
人妻色综合网站
中文字幕无码日韩欧毛
国产欧美精品aa v
欧美高潮抽搐视频在线观看
久久久精品人妻久久影视
国产美女裸体无遮挡免费视频
狠狠v日韩v欧美v
国产丰满麻豆VIDEOSSEX
十八禁视频网站在线观看
午夜亚洲福利在线老司机
欧洲人妻丰满AV无码久久不卡
久久国产精品一国产精品金尊
A国产一区二区免费入口
亚洲av午夜精品无码专区
国产精品麻豆成人AV电影
色综合天天综合高清网国产在线
国产成A人亚洲精V品无码
四虎国产精品成人
人人操人人摸人人干
国产午夜人做人免费视频网站
免费久久一级欧美特大黄
97精品人妻一区二区三区在线
久久亚洲精品无码AⅤ大香
亚洲AV无码国产综合专区
人人妻人人做人人爽三级
无人区码一码二码三码区别新月
91精品隔壁老王在线观看
精品久久人人妻人人做精品
a天天爽夜夜太爽视频精品
久久久亚洲综合久久
国产免费a片视频一区二区三区
国产在线视频XXX
青青草免费在线视频
亚洲欧美偷国产日韩
日韩视频在线观看
最新精品国偷自产在线69
最近日本mv字幕免费高清完整版
国产黄色网站在线免费观看
国产男女爽爽爽免费视频
亚洲性无码AV中文字幕
蜜臀av黑人亚洲精品
日本大胆欧美人术艺术
国产男女猛烈视频在线观看
欧美在线精品免播放器视频
ai亚洲嫩模喷白浆在线观看
337p日本欧洲亚洲大胆69影
中文字幕亚洲制服丝袜
国产精品WWW夜色视频
五月天激情国产综合婷婷婷
亚洲无码国产精品
性做久久久久久久久
最近中文字幕高清中文字幕网
女同久久精品国产99国产精品
2021在线精品自拍
国产免费久久精品99re丫丫一
a天天爽夜夜太爽视频精品
无码人妻丰满熟妇区五十路百度
亚洲色欲综合一区二区三区
久久香蕉麻豆精品99
国产在线观看免费无码
久久久亚洲综合久久
免费A级毛片无码A∨在线视频
欧美日韩色欲色欲色欲XXXX
国产高清露脸AV网址
无码人妻精品一区二区三区下载
国产精品视频艾草网
国产精品害羞卫校小美女
精品一区二区三区四区在线
国产在线精品99一卡2卡
中文字幕丰满乱孑伦无码专区
国产91精品久久久久久
久久久午夜精品福利内容
国精品午夜福利视频
性生生活大片又黄又
欧美日韩一区二区三区高清
成人乱码一区二区三区AV
国产一级特黄高清AAAA大片
国产免费无码又爽又刺激高潮软件
国产精品久久久久久无码五月
亚洲Av无码专区国产乱码在线
国产帅男男gay网站视频
欧美最猛黑人xxxx黑人猛交98
欧美性开放BBW
亚洲熟妇少妇任你躁在线观看
国产精品十八禁在线观看
国产黄A三级三级三级看三级
东方四虎av在线观看
久久久精品人妻久久影视
色偷偷av男人的天堂京东热
欧美日韩国产综合第一区
亚洲一区无码精品色
亚洲欧美乱日韩乱国产
国产精品久久AV免费观看
欧美亚洲一区二区在线播放
国产野外强奷系列 在线播放
乱中年女人伦av
厨房掀起裙子从后面进去视频
精品国产91久久
久久久久9999国产精品
国产a级特黄的片子69影院
日韩少妇一级 片内射视频
天天想你在线视频免费观看高清版
亚洲AV无码精品色午夜
精品国产高清在线看国产毛片
国产精品碰碰人人A久久
A片免费观看国产片久久
狠狠色噜噜狠狠狠8888米奇
56prom精品视频在放免费
国产丰满老熟女60岁重口对白
久久香蕉国产线看观看精品蕉
最近免费中文字幕MV免费高清版
美女张开腿让人桶
久久久久99人妻一区二区三区
性欧美三级在线观看
一本大道色卡1卡2卡3
99久久伊人精品综合观看
中文热免费在线视频
2022年国产精品每日更新
国产精品人人做人人爽人人添
精品国产免费二区二区
蜜臀av在线
韩国三级电影在线为你提供好看的韩国三级
亚洲AV高清无码
高清无码一级片在线看
久久精品中文闷骚内射
天堂8资源在线官网资源
欧美v亚洲v日韩在线播放
亚洲国产aⅴ成人精品无吗
超91福利国产在线观看
国产刺激真实乱对白
色偷偷av男人的天堂京东热
国产欧美亚洲精品一区二区三区
西西444www高清大胆
精品久久久久久综合日本
精品久久人人妻人人做精品
日本老肥婆bbbwbbbwzr
永久免费的AV网无码播放
亚洲中文字幕va毛片
久久精品分类视频
最新无码人妻不卡中文字幕
性人久久久久
尤物久久99国产精品福利
五十六十日本老熟妇乱
国产精品免费久久久久电影
午夜亚洲福利在线老司机
免费国产一级a片v
日韩高清在线亚洲专区
最新国产防屏蔽入口地址
国产午夜福利AⅤ在线机视频
免费观看av片在线手机观看
人人妻人人澡人人爽欧美一区九九
国产在线中文字幕
99噜噜噜在线播放
国产精品毛片大码女人
亚洲成av人片一区二区三区
国内精品自线一区二区三区2021
激情xo无码免费视频
国产AV无码专区亚汌A√
欧洲熟妇色XXXX欧美老妇软件
精品中文高清在线HD免费
国产日韓无码一区二区三区久久区
香蕉网伊在线中文字青青
99久久夜色精品国产网站
亚洲人成网站在线观看播放
国产欧美日韩精品丝袜高跟鞋
久久国产精品-国产精
国产日韩欧美视频APP
欧美日韩综合在线精品
少妇偷人精品视频免费
欧美日韩国产内地在线
日韩全网无码视频
欧美精品国产精品
亚洲国产的日韩a级片亚洲
男人女人黄 色视频免费
伊人久久大香线蕉成人
久久久久无码精品国产不卡
精品国产免费二区二区
亚洲AV无码专区国产乱码电影
国产三级av在线播放
久久精品综合国产二区
国产精品自产拍在线18禁青青
国产婷婷精品av在线
在线观看AV永久免费
777精品久无码人妻蜜桃
优优人体大尺大尺无毒不卡
强姧伦久久久久久久久
日韩精品中文一区二区
亚洲av美国av产亚洲av图片
无码网站天天大爽免
琪琪视频在线观看
国产精品永久免费
国产9 9在线 | 中文
多人灌满精子怀孕高h
亚洲国产一区二区精品专区发布
精品精品亚洲高清a毛片
最好看的2019年中文字幕视频
国产精品久久国产精麻豆99网站
99精品国产一区二区三区
国产成人综合中文精品
免费a级毛片无码专区
国产精品视频久久
国产精品白丝久久av网站
三上悠亚福利一区二区
中文字幕有码在线视频擁有海量的影視資源
成年片免费观看网站免费观看
一级a毛片免费观看久久精品
97人洗澡人人澡人人爽人人
国产精品久久国产精麻豆99网站
三上悠亚在线精品二区
中文在线中文资源
亚洲另类国产欧美一区二区
少妇真实被内射视频三四区
久久狠狠色噜噜狠狠狠狠97
色欲AV在线中文字网站
综合亚洲色hezyo国产
成年人a级毛片无码免费真人中文字幕
亚洲日韩精品无码专区网址
国产精品毛片大码女人
无码任你躁久久久久久
精品国产精品亚洲一本大道
国产av一区最新精品
久久精品亚洲欧美va
国产精品99中文字幕
国产免费v再看一级A片
麻豆画精品传媒2021网站入口
人妻无码一区二区不卡无码av
91精品国产免费久久国语麻豆
欧美精品xxxxbbbb
国产AV福利第一精品
人妻美妇疯狂迎合系列视频
国产中年熟女大集合
日韩精品中文一区二区
日韩av午夜在线观看
精品国产日韩一区二区三区
成 人 免费 黄 色 网站无毒下载
在线观看澳门三级片av
免费国产美女一级A作爱
多人灌满精子怀孕高h
亚洲成av人片一区二区三区
色噜噜人体337P人体
久久久精品人妻久久影视
不卡高清AV手机在线观看
公与秀婷厨房猛烈进出视频
最近完整中文字幕大全高清
国产蝌蚪免费精品视频动漫
东方四虎在线观看av
午夜爽喷水无码成人18禁三级
中文av国语对白
伊人色综合网久久天天
日韩精品视频一区
日韩无码高清三区免费
亚洲乱码中文字幕手机在线
久久精品国产欧美日韩
少妇高清不卡无码
国产成人久久AV免费
久久久久99人妻一区二区三区
久久精品国产欧美日韩亚洲
中文无码一区二区不卡av
天天拍夜夜添久久精品
亚洲国产初高中生女av
国产乱子伦在线观看
亚洲人成综合第一网
欧美伊香蕉久久综合网另类
亚洲精品无码成人片久久不卡
国产男女猛烈视频在线观看
九九在线视频精品九九一
成全动漫在线观看免费观看
在线免费播放av观看
国产精品视频久久
巨大黑人极品video
伊人色综合网久久天天
黑人大荫道BBWBBB高潮潮喷
国产精品亚洲综合一区在线
国产精品一区高清在线观看
人妻夜夜爽天天爽三区麻豆AV网站
久久91精品牛牛
日本做受高潮好舒服视频
亚洲av乱码一区二区
V一区无码内射国产
国产日韩欧美视频APP
乱码中文字幕a∨在线
国产欧美日韩中文久久
处破女A片免费观看
97中文字幕久久久久综合久久久
最新国产资源片在线观看
国产在线观看AV在线
人人妻人人澡人人爽国产一区
最近中文字幕mv高清在线
51妺嘿嘿午夜福利
欧美xxxxhd高清
亚洲成av人在线观看无堂无码
51妺嘿嘿午夜福利
久久无码高潮喷水亚洲
成全动漫在线观看免费观看
国产精品美女久久久久av超清
熟妇高潮一区二区三区
在线视频亚洲欧美
久久国产Av无码一区二区
人人妻人人狠人人爽
99国产强伦姧在线看Rape
欧美精品国产精品
国产日韓无码一区二区三区久久区
在线精品无码一区二区
日本一道久久道看
图片区小说区av区
91麻豆精品国产自产精品观看
久久国产精品偷中文
无码h肉动漫在线观看免费中文
av人摸人人人澡人人超碰下载
国产成人精品一 二区
天天躁日日躁狠狠躁日日躁
日韩成人精品
一级毛片黄片A级高清
久久婷婷五月综合色高清
国产成人久久AV免费
狠狠色噜噜狠狠狠8888米奇
高H禁伦餐桌上的肉伦
国产精品av中文字幕
亚洲免费一区二区av
国产免费AV片在线观看浪潮
91亚洲一区二区三区在线无码
久久久久亚洲AV无码尤物
亚洲超清无码制服丝袜αv
日本久久99成人网站
日韩av综合免费在线
久久久噜噜噜久久免费
99精品国产在热2019国产
亚洲av日韩精品三区
久久青草精品38国产
国产午夜福利不卡在线秋霞秋霞
久久精品九九亚洲精品
99精品国产中文字幕
欧美黄网站色视频免费
国产亚洲精品麻豆一区二区
亚洲另类日韩国产综合
精品国产自产久久久
成全动漫在线观看免费观看
久久亚洲色www成人
亚洲精品国产精华液怎么样
婷婷五月六月在线中文字幕
欧美喂奶吃大乳
成人无码区在线观看
在线天堂资源www在线污
亚洲精品国产精品乱码在线
欧美又粗又大XXXXBBBB疯狂
在线中文字幕第一页
成全免费高清观看在线电视剧
久久久久精品电影一区二区三区
国产区最新2021网站
亚洲图综合专区20p
青青视频在线观看
先锋稳定亚洲每日资源网
性生交片免费无码看人
麻豆亚洲AV成人无码久久精品
中文在线中文资源
了解最新在线看片国内自拍视频信息!
欢迎访问久久国产精品无码一级毛片
国产成人精品午夜福利
av亚洲一区二区在线
国产人与动牲交a
欧美性xxxxx极品
国产在线自在拍91有声
成全动漫视频在线观看
午夜大尺度精品福利视频
亚洲一区二区观看播放
主人~别揉了~尿了~啊哈视频
色哟哟网站在线观看
牲欲强的熟妇农村老妇女视频
精品一区二区三区av无码
七色影视无码激情在线
成在线人永久免费视频播放
99噜噜噜在线播放
亚无码乱人伦一区二区
国内精品久久人妻无码妲己影院
巨茎爆乳无码性色福利
久久天天躁狠狠躁夜夜97
国产精品护士
青草青青精品视频网站
久久精品国产欧美日韩亚洲
蜜臀AⅤ永久无码精品
欧美精品国产精品
日本欧美中文字幕精品一区
日本道色综合久久影院
欧美97久久人人模人人爽人人
无码任你躁久久久久久
久久精品无码一区二区三区不卡
国产普通话对白刺激
日本道色综合久久影院
欧美 国产 精品 一区二区南
国产人与ZOXXXX另类
国产成人久久精品激情
欧美高潮抽搐视频在线观看
最近中文字幕mv高清在线
成人午夜av在线播放
久久人人97超碰男呻吟
欧美最猛黑人xxxx黑人猛交98
少妇精品久久久久www
国产精品福利在线播放
欧美18ⅩXXXX性欧美喷水
成人无码区在线观看
麻豆视频国产区直接观看
xxxxbbbb欧美
国产精品福利在线播放
亚洲国产欧美日韩欧美特级
男女车车的车车网站W98免费
开心色怡人综合网站
Av人妻一区二区三区
2020青草国产9r在线
国产自啪精品视频网站丝袜
免费A级毛片无码视频
国产欧美亚洲精品a
人妻丰满熟妇岳AV无码区HD
人人妻人人妻人人片色av
日本韩国免费在线手机电影
亚洲成人综合网站777香蕉
久久精品高清一区二区三区
国产男女猛烈视频在线观看
国产精品白丝久久av网站
久久美女大胆嘘嘘嘘国产盗摄
五月天婷婷丁香中文字幕
777亚洲精品乱码久久久久久
国产中文一区二区
国产a级三级三级三级
国产一区二区精品久久呦
亚洲精品香蕉婷婷在线观看
日韩成人精品
2020国产在线拍揄自揄视频
四虎国产精品成人
国产成人精品高清在线电影
午夜精品一区二区三区免费视频
亚洲欧美日韩综合二区在线麻豆
国产亚洲午夜高清
无码AV中文一区二区三区
老熟女重囗味hdxx69
国产重口老太和小伙
少妇激情a∨一区二区三区
国产成人精品无码片区在线观看
日本丰满白嫩大屁股ASS
丰满少妇被粗大猛烈进人高清
公交车上~嗯啊被高潮视频软件
jlzzjlzz亚洲乱熟在线播放
视频一区二区在线观看
玖玖爱在线视频这里只有国产中文精品39
老司机在线网站
韩国精品无码一区二在线
免费无码在线观看
色哟哟网站在线观看
羞答答的玫瑰在线观看
久久国产福利播放
亚洲伊人久久大香线蕉综合图片
三上悠亚福利一区二区
亚洲av中文无码网站
樱桃视频大全免费观看
亚洲一区二区观看播放
911青草亚洲精品
国产成人精品午夜福利
久久这里只有精品最新地址
国产免费午夜福利在线网址
国产最新进精品视频
日本欧美中文字幕精品一区
爱插免费视频在线观看
zyz玖玖资源站免费中文
免费无码av片在线观看
国产午夜人做人免费视频网站
国产日韩在线欧美成人
在线观看AV永久免费
久久av免费天堂小草播放
色综合视频一区二区观看
国产午夜三级一区二区三
美女黄网站免费
亚洲欧美中文日韩v在线观看
99精品视频在线观看免费播放
国产又粗又大又爽视频
91精品91久久久中文字幕AⅤ
日韩精品一区二区在线观看
亚洲AV日韩AV永久无码久久
亚洲AV无码专区在线观看下载
国产亚洲精品第一综合另类
人妻天天爽夜夜爽一区二区
无码AV免费一区二区三区
人妻少妇乱子伦无码视频专区
开心色怡人综合网站
精品国产品香蕉在线
久久久久人妻一道无码AV
免费无码又爽又刺激网站
久久精品九九亚洲精品
玩弄放荡人妻少妇系列视频
激情综合五月网
国产无遮挡吃奶视频网站
多人灌满精子怀孕高h
国产午夜精品理论片
四虎影院176
欧美在线精品免播放器视频
亚洲线精品一区二区三区影音先锋
AV人摸人人人澡人人超碰妓女
菠萝菠萝蜜在线观看视频社区
国产—级a片无码
亚洲精品中文字幕乱码影院
最近中文字幕2019免费版日本
八区精品色欲人妻综合网
亚洲无码V久久码
国产亚洲精品第一综合另类
国产无缓冲a片视频
国产自啪精品视频网站丝袜
免费大片一级a一级久久
亚洲国产精品一区二区九九
韩国三级+mp4
色婷婷视频在线观看
亚洲免费无码小视频
少妇真实被内射视频三四区
久久婷婷五月综合色高清
av色欲无码人妻中文字幕
亚洲av乱码中文一区二区三区
精品三级久久久久久久电影聊斋
性XXXX在线观看免费视频
精品国富产二代app官方入口
国模和精品嫩模私拍视频
97超碰国语国产97超碰
强开小婷嫩苞又嫩又紧韩国视频
国产精品一线二线三线有什么区别
亚洲国产另类精品18
成人精品一区二区三区中文字幕
中文字幕不卡二区亚洲
综合久久中文精品视频
国产精品一区二区av片
狠狠色噜噜狠狠狠8888米奇
先锋稳定亚洲每日资源网
成人夜色视频网站在线观看
吸咬奶头狂揉60分钟视频
亚洲图综合专区20p
国产精品ⅤA在线观看
免费高清自慰区
久久国产精品无码一区
国自产偷精品不卡在线
伊人久久综合线亚洲2019
日韩精品一区二区在线观看
亚洲精品无码成人片久久不卡
久久精品无码一区二区三区免费
欧美日韩国产综合第一区
黄片在线免费观看
97伊人久久超碰
日韩不卡无码人妻视频一区
潮喷无码正在播放
国产午夜人做人免费视频
97国产无线乱码在线观看
国产日韩在线欧美成人
91亚洲一区二区三区在线无码
国产成人综合亚洲欧美日韩
国产精品igao视频
精品国富产二代app官方入口
欧美刺激性大交
人妻中文av无码。久久
精品人妻一区二区三区浪潮在线
国产深喉口爆一区二区三区
综合亚洲色hezyo国产
一本大道在线一本久道视频
一区二区三区在线免费看
短篇公交车高H肉辣全集目录
91中文字幕在线
久久av嫩草影院
青青草国产线观看
av亚洲在线一区二区
无码乱码av天堂一区二区